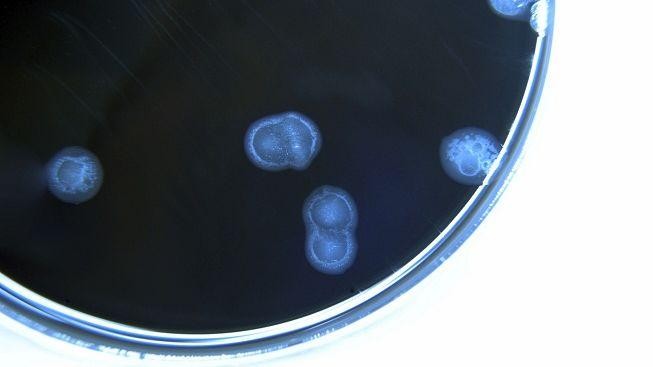
Nejlepší restaurace na světě v maléru: 60 hostů si zkazilo žaludek

Nejlepší restaurace na světě v maléru: 60 hostů si zkazilo žaludek
8. 3. 2013 – 19:44 | Zpravodajství | Michal Polák
Na návštěvu "nejlepší restaurace na světě" určitě dlouho nezapomene nejméně 63 hostů kodaňské restaurace Noma vyznamenané dvěma michelinskými hvězdičkami. Po kulinářském zážitku v podniku, kde se na rezervaci zpravidla čeká i několik měsíců, je totiž postihly zvracení a průjmy, informovala dnes agentura DPA.
Obchodní šéf restaurace Peter Kreiner vyjádřil v televizi DR nad tím hluboké politování a řekl, že vedení podniku už navázalo kontakt s postiženými hosty, mimo jiné i kvůli jejich peněžnímu odškodnění. Zdroj nákazy, která způsobila zdravotní potíže některým hostům v období od 12. do 16. února, nebyl podle Kreinera ještě jednoznačně potvrzen. Pravděpodobně prý ale šlo některého z pracovníků, který neměl tušení o tom, že je nakažlivý.
Restaurace Noma v kodaňském přístavu, v jejímž čele stojí dánsko-albánský šéfkuchař René Redzepi, byla v letech 2010, 2011 a 2012 britským časopisem Restaurant Magazine vyhlášena nejlepší světovou restaurací.